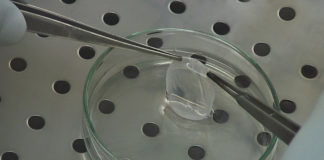
Italy leader in the regenerative medicine field with Holoclar

New therapeutic opportunity
Mechanisms of acquired resistance to anti-EGFR targeted therapies in metastatic colorectal...
Here is an extract of the doctoral thesis whereby Sandra Misale received the award "Marisa Colbacchini" established by Asis (Associazione Studi sull'Industria della Salute) and Carlo Erba Foundation for PhD researchers in oncology
Pharmaceutical raw materials
A special chance for innovation and investments
The unique macroeconomical framework should help the Italian manufacturers of pharmaceutical raw materials to strengthen their leading position in the field. Investments and institutional support is needed to overcome the bottlenecks that still slow down foreign investments in Italy. The president of Aschimfarma Gian Mario Baccalini comments the current trends.Italy leader in the regenerative medicine field with Holoclar
The collaboration between public research and a private pharmaceutical enterprise has reached an amazing achievement “made in Italy”: the first drug based on stem cells authorized in Europe
Formulation technology